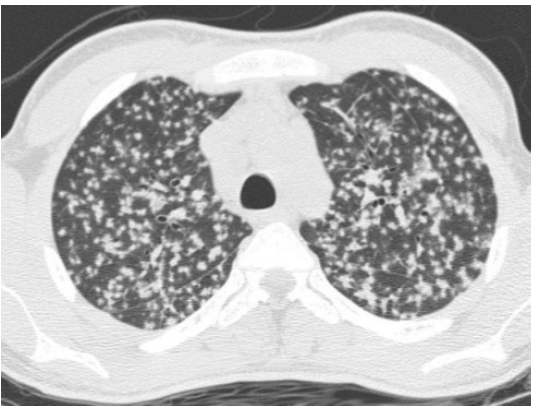

Polmone più o meno normale, forma tronco-conica a base maggiore inferiore (base),
chiaramente una sola scissura, lateralità rapporto tra le strutture vascolari e i bronchi, macchie per
problemi di fissazione, piccoli noduli antracotici (normale in un polmone di una persona che vive in
città

Cuore polmonare cronico aumentato di dimensioni con camere ventricolari dilatate bilateralmente e
pareti ventricolari ispessite.
Ipertensione polmonare
- Idiopatica
- Cardiaca (stenosi mitralica)
- Pneumopatie (BPCO ed asma)
- Tromboembolia polmonare
- Obesità (apnee notturne)

Arteria polmonare con trombo-embolia.

INFARTO POLMONARE
Descrizione: Forma del polmone normale e anche dimensioni e volume, vi è un’alterazione del
colore del polmone di forma triangolare con la base verso la pleura e l’apice verso le strutture
dell’ilo, il colore è rosso bruno scuro, è un problema che riguarda l’irrorazione. L’infarto del polmone
è di tipo emorragico mentre negli infarti ischemici l’area interessata è pallida mentre nel parenchima
cerebrale e nel polmone l’area interessata è scura, raramente anche l’infarto del rene.

BRONCHITE CRONICA
Descrizione: Bronco con tappo mucoso. Apertura del bronco, nella patologia polmonare quando si
osserva l’organo, dopo averlo descritto da fuori, si aprono le strutture bronchiali e le strutture
arteriose e venose per vedere cosa c’è dentro, se ci sono trombi (tromboembolia polmonare, TVP o
CID). Nei bronchi è possibile ritrovare cibo (polmonite ab ingestis) oppure del muco in patologie di
tipo ostruttivo come la bronchite cronica e BPCO.

ENFISEMA POLMONARE
Descrizione: Enfisema polmonare centroacinare. Trama del parenchima polmonare con irregolarità
della struttura alveolare della struttura alveolare e distruzione dei setti.

BRONCHIECTASIE POLMONARI
Descrizione: Polmone con strutture bronchiali dilatate e focolai di broncopolmonite.

BRONCHIECTASIE POLMONARI
Descrizione: Polmone con strutture bronchiali dilatate e focolai di broncopolmonite.

FIBROSI POLMONARE
Descrizione: Parenchima polmonare con aumento della trama alveolare per fibrosi dei setti.

ANTRACOSI POLMONARE
Descrizione: Polmone con depositi diffusi di pigmento nero. DD noduli con addensamenti, ben
definiti, linfonodi ingranditi se si legge una radiografia di un radiologo che referta un antracosi:
“noduli multipli con aumento delle dimensioni del linfonodo”, con anamnesi si escludono le
metastasi e può essere utilizzata anche la biopsia per avere la conferma.

SILICOSI POLMONARE
DESCRIZIONE:
Il pezzo anatomico raffigura una porzione di polmone; sono visibili dei bronchi tagliati trasversalmente e
l’ilo. Il tipico aspetto spugnoso polmonare è sostituito dalla presenza di noduli fibrosi di colore grigiastro,
soprattutto nei lobi superiori (con il sovrapporsi dell’antracosi è grigio/nero).

Asbestosi polmonare
DESCRIZIONE:
Pezzo anatomico con forma non del tutto conservata, ma si vede un aspetto lucido (pleura). Dalle
conformazioni si potrebbe pensare a una sezione trasversale del polmone, che mostra la parte
diaframmatica. Sono visibili le basi. Risultano evidenti 4 placche biancastre (ispessimenti nodulari
multifocali) fibrocalcifiche di dimensioni variabili. Sono bilaterali, a livello della pleura parietale con margini
netti à ASBESTOSI

Sarcoidosi Polmonare
Polmoni con noduli
multipli fibrosi in rapporto ai grossi bronchi.
DESCRIZIONE:
Forma conservata, si vedono POLMONI, TRACHEA, LINFONODI ILARI, VASI, BRONCHI. Vicino ai grossi
bronchi si vedono lesioni (noduli) scure, con limiti netti. Sono interessati anche i linfonodi ilari à sarcoidosi

Broncopolmonite polmonare (15-16-17)
IMMAGINI 15-16
Polmone con focolai multipli di addensamento del parenchima.
DESCRIZIONE:
Il pezzo anatomico è tagliato longitudinalmente, di forma conservata a cono rovesciato à polmone. Una
sola scissura quindi si parla di polmone sinistro(?). il parenchima ha dei focolai di addensamento
parenchimale multipli, bilaterali, multilobari con margini mal definiti à Broncopolmonite. La
broncopolmonite da addensamento parcellare del polmone con focolai multipli di consolidamento. Le zone
sono grigio. Rosso/giallo. L’essudato è fibrino-leucocitario e coinvolge bronchi e alveoli.

Broncopolmonite polmonare (15-16-17)
IMMAGINI 15-16
Polmone con focolai multipli di addensamento del parenchima.
DESCRIZIONE:
Sono apprezzabili aree più chiare che appaiono in rilievo sulla superficie di taglio rispetto al polmone
circostante. Presenta aree di consolidamento polmonare.

POLMONITE LOBARE
Descrizione: Polmone con addensamento parenchimale dell’intero lobo.DESCRIZIONE:
Pezzo anatomico tagliato longitudinalmente con forma a cono rovesciato à polmone. In basso si ha una
zona grigio-traslucida, area di consolidamento dell’intero lobo, potrebbe essere una polmonite lobare con
epatizzazione * grigia. La pleura sovrastante è opaca per deposizione di fibrina.

Epatizzazione rossa: il lobo appare compatto, rossastro (epatizzazione)
Macro: area di consistenza aumentata, non aerata, color mattone
Microscopicamente c’è essudato endoalveolare di emazie, fibrina e granulociti neutrofili
Descrizione: Parenchima polmonare con
addensamento parenchimale localizzato ad un
lobo di colore rosso vivo e di aspetto congesto.

Epatizzazione grigia: il lobo appare compatto, bianco-grigiastro
Macroscopicamente: Il parenchima polmonare interessato rimane di consistenza aumentata ed il
colorito vira verso il grigio per il disfacimento delle emazie e l’accumulo di fibrina.
Microscopicamente le emazie non sono più visibili (lisate) e l’alveolo contiene fibrina e neutrofili
Descrizione: Parenchima polmonare con
addensamento parenchimale localizzato ad un
lobo di colore rosso vivo e di aspetto congesto.
Descrizione: Parenchima polmonare con
addensamento parenchimale localizzato ad un lobo
di colore roseo ed aspetto asciutto.

ASCESSO POLMONARE
Descrizione: Polmone con focolai multipli di broncopolmonite e cavità ascessualizzata.

TUBERCOLOSI POLMONARE
Descrizione: Lesione nodulare calcifica del parenchima polmonare e calcificazione dei linfonodi
perilari (complesso di Ghon).

TUBERCOLOSI POLMONARE
Descrizione: Lesione nodulare calcifica del parenchima polmonare e calcificazione dei linfonodi
perilari (complesso di Ghon).

TUBERCOLOSI POLMONARE
Descrizione: Lesione nodulare calcifica del parenchima polmonare e calcificazione dei linfonodi
perilari (complesso di Ghon).
TUBERCOLOSI POLMONARE
Descrizione: Lesione nodulare calcifica del parenchima polmonare e calcificazione dei linfonodi
perilari (complesso di Ghon).

CARCINOMA A CELLULE SQUAMOSE DEL POLMONE
Descrizione: Porzione di parenchima polmonare con lesione nodulare fibrosa in continuità con il
bronco. Si tratta di un carcinoma squamocellulare in quanto parte dal bronco, c’è una resezione di
una porzione di trachea ed a livello della biforcazione dei bronchi è presente una massa che ha forti
rapporti con il bronco, ovalare di dimensioni con necrosi centrale.








